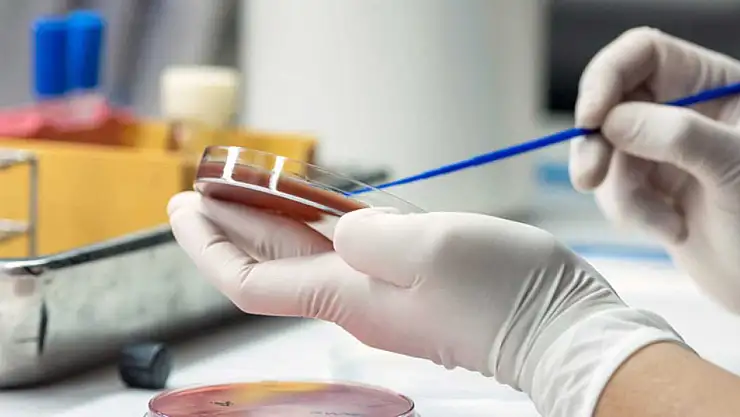
Sağlık Müdürlüğü Sepsis Hastalığına dikkat çekti

Sağlık Müdürlüğü Sepsis Hastalığına dikkat çekti
Sepsis'e dikkat..
Bartın İl Sağlık Müdürlüğü yaptığı açıklamada Sepsis hastalığına karşı uyarılarda bulundu.
Vücudun herhangi bir yerinde meydana gelen enfeksiyona karşı bağışıklık sisteminin aşırı tepki vermesinden dolayı oluşan Sepsis hastalığına karşı vatandaşları uyaran Bartın İl Sağlık Müdürlüğü açıklamasında şu ifadelere yer verdi; “Sepsis, vücudun herhangi bir yerinde gelişen enfeksiyona karşı bağışıklık sisteminin verdiği abartılı tepkidir. Bu tepki doku ve organlarda hasar meydana getirir. Sepsise virüs, bakteri, mantar vb. etkenler sebep olabilir. Sepsis açısından risk grupları ise şöyle, kronik hastalığı olanlar, 1 yaşından küçük olanlar, 60 yaşından büyük yetişkinler, dalağı bulunmayanlar, bağışıklık sistemi baskılanmış olanlar.”